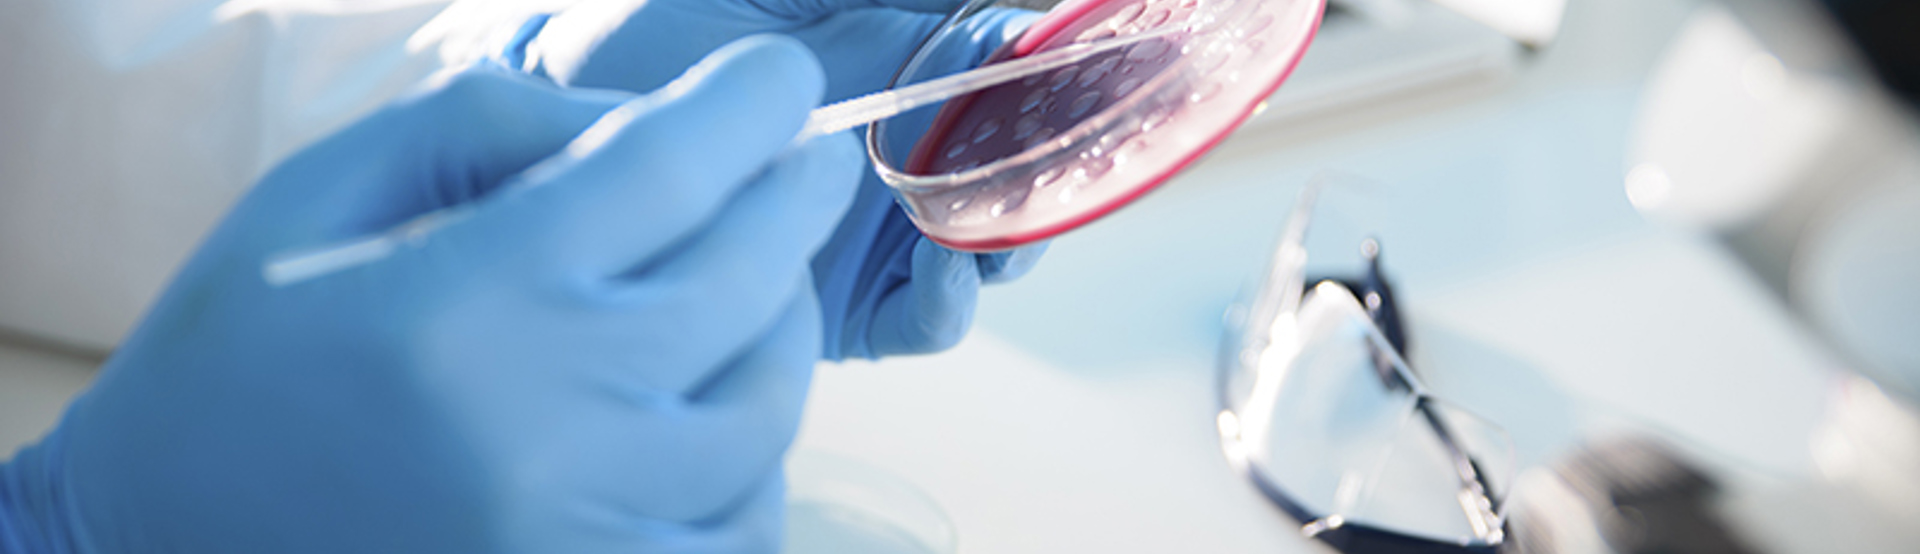
Research Petri Science Istock 000046565740XXX

Research
28 Sep 2021Combining existing treatments can improve survival in men with localised and advanced prostate cancer.
Results from two major trials could change the way we treat prostate cancer. We look at what these findings mean for men and their families.
As well as developing new treatments, another way we’re trying to speed up progress against prostate cancer is by trialling existing treatment combinations at different stages of the disease.
Two exciting trials in this area, STAMPEDE and PEACE-1, had results presented by researchers at the ESMO (European Society for Medical Oncology) annual conference, and the great news is that both have shown significant benefit compared to standard treatments.
STAMPEDE trial: new combinations to treat aggressive, localised prostate cancer
Abiraterone is a drug that’s currently only used once cancer has spread and is not responding to other hormone therapies. But the latest results from the STAMPEDE trial show that giving abiraterone to men with localised disease that’s at high-risk of spreading, significantly reduced the number of men whose cancer did spread, and crucially, reduced the number who died from prostate cancer within six years by more than half (from 15% to 7%).
Given these results, we hope to see abiraterone made available to these men much earlier in their treatment.
Dr Matthew Hobbs, Director of Research at Prostate Cancer UK, said: “Too many men are dying from prostate cancer, and it is vital that we find new ways to help prevent it from spreading and becoming lethal.
“We now hope to see abiraterone made available on the NHS for this group of men and look forward to seeing more research published by this impressive study. That’s why Prostate Cancer UK is providing £2.5 million in funding to help the researchers leading this trial to target prostate cancer treatments to work out which men will benefit most.”
PEACE-1 trial: new combinations to treat advanced prostate cancer
Results published from the PEACE-1 trial last weekend show that a new combination of prostate cancer treatments could extend the lives of men with advanced disease by up to 18 months.
In recent years, several new treatments have been approved for hormone sensitive advanced prostate cancer (when cancer has spread past the prostate and around the body, but it can be treated with hormone therapy) - including docetaxel chemotherapy and abiraterone - which have significantly improved life expectancy. The results from the PEACE-1 trial take this one step further and show that giving both drugs at the same time alongside traditional hormone therapy can provide even greater benefit.
With two of these treatments already off-patent and one due to follow in the next 18 months, this should not only prove very beneficial for men, but affordable for the NHS as well. Once the full results are published, we'll look to work with NICE and others to make sure this combination becomes the new standard of care for these men.
Dr Matthew Hobbs said: “Prostate cancer research has made great strides in recent years in improving treatments for men with advanced prostate cancer. This study builds on that progress and shows that combining several new treatments can give men up to 18 months of additional life. This will make a huge difference for these men, and if the full results confirm these findings, we want to see this combination approved on the NHS as quickly as possible.”
This will make a huge difference for these men, and if the full results confirm these findings, we want to see this combination approved on the NHS as quickly as possible.
How we’re giving men access to these life-extending combinations
It’s thanks to your ongoing support, that we’re able to fund and support innovations like these. We’ve invested over £2.5m into the STAMPEDE researchers across four different grants to analyse data, samples, and images from that trial to work out exactly which men will benefit most. The aim is to target the drugs more precisely, so men get maximum benefits while minimising the potential side effects. It’s hugely encouraging to see such sustained progress, and improvements to treating prostate cancer that will give men longer with their families, friends and loved ones. However, we must not stop here - we know that with sustained funding for research we can drive even more progress from these clinical trials, and many others.
You can help us improve diagnosis, treatment, and care for men everywhere by giving a regular gift. Together, we can stop prostate cancer limiting lives.